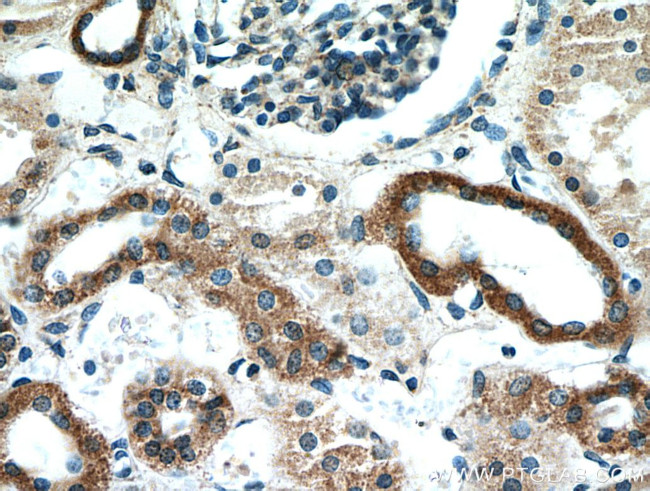
TACO1/CCDC44 Antibody in Immunohistochemistry (Paraffin) (IHC (P))

Search
Proteintech
TACO1/CCDC44 Polyclonal Antibody
{{$productOrderCtrl.translations['antibody.pdp.commerceCard.promotion.promotions']}}
{{$productOrderCtrl.translations['antibody.pdp.commerceCard.promotion.viewpromo']}}
{{$productOrderCtrl.translations['antibody.pdp.commerceCard.promotion.promocode']}}: {{promo.promoCode}} {{promo.promoTitle}} {{promo.promoDescription}}. {{$productOrderCtrl.translations['antibody.pdp.commerceCard.promotion.learnmore']}}
产品信息
21147-1-AP
种属反应
已发表种属
宿主/亚型
分类
类型
抗原
偶联物
形式
浓度
规格
纯化类型
保存液
内含物
保存条件
运输条件
产品详细信息
Immunogen sequence: MSAWAAASL SRAAARCLLA RGPGVRAAPP RDPRPSHPEP RGCGAAPGRT LHFTAAVPAG HNKWSKVRHI KGPKDVERSR IFSKLCLNIR LAVKEGGPNP EHNSNLANIL EVCRSKHMPK STIETALKME KSKDTYLLYE GRGPGGSSLL IEALSNSSHK CQADIRHILN KNGGVMAVGA RHSFDKKGVI VVEVEDREKK AVNLERALEM AIEAGAEDVK ETEDEEERNV FKFICDASSL HQVRKKLDSL GLCSVSCALE FIPNSKVQLA EPDLEQAAHL IQALSNHEDV IHVYDNIE (1-297 aa encoded by BC007744)
靶标信息
TACO1 is a mitochondrial translational activator required for efficient translation of cytochrome c oxidase (Weraarpachai et al., 2009), a component of complex IV of the mitochondrial respiratory complex.
仅用于科研。不用于诊断过程。未经明确授权不得转售。
生物信息学
蛋白别名: clone HQ0477 PRO0477p; coiled-coil domain containing 44; Coiled-coil domain-containing protein 44; coiled-coil domain-containing protein 44 {ECO:0000312|EMBL:AAI66900.1}; taco1 {ECO:0000250|UniProtKB:Q9BSH4}; translational activator of COX I; Translational activator of cytochrome c oxidase 1; translational activator of cytochrome c oxidase 1 {ECO:0000250|UniProtKB:Q9BSH4}; translational activator of mitochondrially encoded cytochrome c oxidase I; Translational activator of mitochondrially-encoded cytochrome c oxidase 1; Translational activator of mitochondrially-encoded cytochrome c oxidase I; translational activator of mitochondrially-encoded cytochrome c oxidase I {ECO:0000250|UniProtKB:Q9BSH4}; unnamed protein product
基因别名: 2310066I18Rik; CCDC44; MC4DN8; PRO0477; RGD1306784; TACO1
UniProt ID: (Human) Q9BSH4, (Rat) B2RYT9, (Mouse) Q8K0Z7
Entrez Gene ID: (Human) 51204, (Rat) 360645, (Mouse) 70207